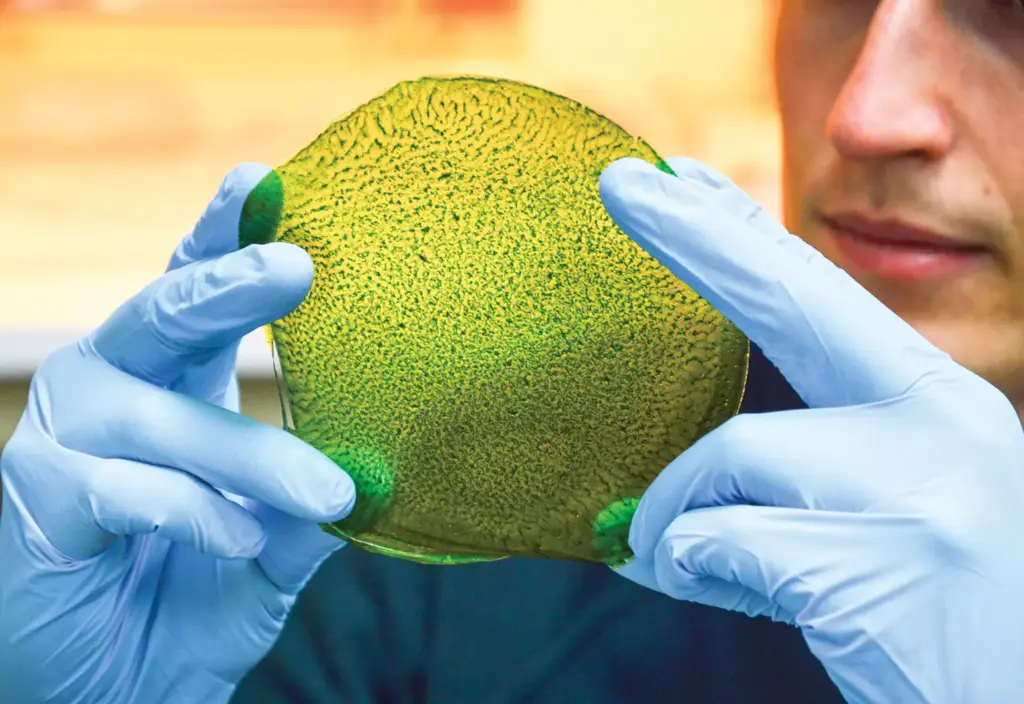

Cambridge Üniversitesi araştırmacıları tarafından geliştirilen ve “yüzyılın icadı” olarak nitelendirilen Yapay Yaprak (Artificial Leaf) teknolojisi, İngiltere’deki dev bir endüstriyel serada ilk kez ticari ölçekli hasat vermeyi başardı. Bu teknoloji, bitkilerin fotosentez yapma ihtiyacını tamamen ortadan kaldırarak karanlıkta besin üretiminin yolunu açıyor.
1. Fotosenteze Rakip Geldi: “Asetat” Devrimi
Doğa, güneş enerjisini besine dönüştürmek için fotosentezi kullanır; ancak bu süreç güneş enerjisinin sadece %1’ini verimli kullanabilir.
- Süreç Nasıl Çalışıyor? Araştırmacılar, güneş enerjisini doğrudan “asetata” (bitkilerin ana enerji kaynağı olan molekül) dönüştüren iki aşamalı bir elektrokatalitik sistem kurdular.
- Karanlıkta Üretim: Bitkiler (bu testte domates, pirinç ve mantar kullanıldı), güneş ışığına hiç ihtiyaç duymadan, köklerine verilen bu “sıvı enerji” (asetat) ile tamamen karanlık odalarda büyütüldü.

2. %400 Daha Fazla Verim
Bugün açıklanan test sonuçlarına göre, “Yapay Yaprak” yöntemiyle yetiştirilen bitkiler, güneş ışığıyla büyüyen hemcinslerine göre 4 kat daha hızlı büyüdü ve çok daha az su tüketti.
- Neden Önemli? Bu yöntem, tarım için devasa arazilere ve mükemmel iklim koşullarına olan ihtiyacı bitiriyor. Çöllerin ortasında, kutuplarda veya yeraltı sığınaklarında “süper verimli” tarlalar kurmak artık mümkün.
3. Mars Kolonileri İçin İlk Adım
NASA, bugünkü başarılı hasadın ardından bir açıklama yaparak, bu teknolojinin Mars görevlerinde astronotların besin ihtiyacını karşılamak için kullanılacak temel yöntem olacağını duyurdu. Güneş ışığının zayıf olduğu Mars topraklarında, yapay enerjiyle beslenen kapalı dikey çiftlikler kurulacak.

Bu Neden Bir “Gıda İhtilali”?
Bu haber, insanlığın doğaya olan en temel bağımlılığının—güneş ışığına olan ihtiyacın—kırıldığını görüyorum.
- Gıda Fiyatlarında Çöküş: Eğer mevsim ve arazi kısıtlaması kalkarsa, gıda üretimi “fabrikasyon” bir sürece dönüşür. Bu da lojistik maliyetlerini düşürür ve dünyadaki açlık sorununa son verebilir.
- Tat ve Besin Değeri Sorusu: Laboratuvar ortamında, sadece kimyasal enerjiyle büyüyen bir domatesin tadı, toprakta ve güneşte büyüyenle aynı olur mu? Şahsen, bu teknolojinin ilk aşamada “lezzet” değil, “hayatta kalma” odaklı olacağını düşünüyorum. Gurme restoranlar hala “güneş görmüş” ürünleri pahalıya satmaya devam edecektir.
- Ekosistem Riski: Tarımı tamamen kapalı alanlara taşımak, dışarıdaki tarım arazilerinin kaderini ne yapacak? Doğal dengenin bozulması veya genetik çeşitliliğin azalması riskini de beraberinde getiriyor.
Teknoysi Editör Yorumu: Yüzyıllardır çiftçiler gökyüzüne bakıp yağmur ve güneş bekledi. Bugün ise teknoloji, güneş ışığını bir şişeye hapsedip bitkilere doğrudan içirmeye başladı. Bu, biyolojinin endüstrileştiği en uç noktadır.




